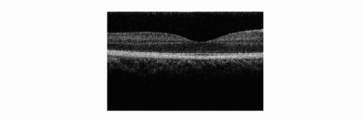

WO2010134342A1 - Imaging device and imaging method - Google Patents
Imaging device and imaging method Download PDFInfo
- Publication number
- WO2010134342A1 WO2010134342A1 PCT/JP2010/003384 JP2010003384W WO2010134342A1 WO 2010134342 A1 WO2010134342 A1 WO 2010134342A1 JP 2010003384 W JP2010003384 W JP 2010003384W WO 2010134342 A1 WO2010134342 A1 WO 2010134342A1
- Authority
- WO
- WIPO (PCT)
- Prior art keywords
- lights
- light
- measuring
- imaging device
- interference
- Prior art date
- Legal status (The legal status is an assumption and is not a legal conclusion. Google has not performed a legal analysis and makes no representation as to the accuracy of the status listed.)
- Ceased
Links
Images
Classifications
-
- A—HUMAN NECESSITIES
- A61—MEDICAL OR VETERINARY SCIENCE; HYGIENE
- A61B—DIAGNOSIS; SURGERY; IDENTIFICATION
- A61B3/00—Apparatus for testing the eyes; Instruments for examining the eyes
- A61B3/10—Objective types, i.e. instruments for examining the eyes independent of the patients' perceptions or reactions
- A61B3/12—Objective types, i.e. instruments for examining the eyes independent of the patients' perceptions or reactions for looking at the eye fundus, e.g. ophthalmoscopes
-
- G—PHYSICS
- G01—MEASURING; TESTING
- G01N—INVESTIGATING OR ANALYSING MATERIALS BY DETERMINING THEIR CHEMICAL OR PHYSICAL PROPERTIES
- G01N21/00—Investigating or analysing materials by the use of optical means, i.e. using sub-millimetre waves, infrared, visible or ultraviolet light
- G01N21/17—Systems in which incident light is modified in accordance with the properties of the material investigated
-
- A—HUMAN NECESSITIES
- A61—MEDICAL OR VETERINARY SCIENCE; HYGIENE
- A61B—DIAGNOSIS; SURGERY; IDENTIFICATION
- A61B3/00—Apparatus for testing the eyes; Instruments for examining the eyes
- A61B3/10—Objective types, i.e. instruments for examining the eyes independent of the patients' perceptions or reactions
- A61B3/102—Objective types, i.e. instruments for examining the eyes independent of the patients' perceptions or reactions for optical coherence tomography [OCT]
-
- A—HUMAN NECESSITIES
- A61—MEDICAL OR VETERINARY SCIENCE; HYGIENE
- A61B—DIAGNOSIS; SURGERY; IDENTIFICATION
- A61B5/00—Measuring for diagnostic purposes; Identification of persons
- A61B5/0059—Measuring for diagnostic purposes; Identification of persons using light, e.g. diagnosis by transillumination, diascopy, fluorescence
- A61B5/0062—Arrangements for scanning
- A61B5/0066—Optical coherence imaging
-
- A—HUMAN NECESSITIES
- A61—MEDICAL OR VETERINARY SCIENCE; HYGIENE
- A61B—DIAGNOSIS; SURGERY; IDENTIFICATION
- A61B5/00—Measuring for diagnostic purposes; Identification of persons
- A61B5/0059—Measuring for diagnostic purposes; Identification of persons using light, e.g. diagnosis by transillumination, diascopy, fluorescence
- A61B5/0075—Measuring for diagnostic purposes; Identification of persons using light, e.g. diagnosis by transillumination, diascopy, fluorescence by spectroscopy, i.e. measuring spectra, e.g. Raman spectroscopy, infrared absorption spectroscopy
-
- A—HUMAN NECESSITIES
- A61—MEDICAL OR VETERINARY SCIENCE; HYGIENE
- A61B—DIAGNOSIS; SURGERY; IDENTIFICATION
- A61B5/00—Measuring for diagnostic purposes; Identification of persons
- A61B5/44—Detecting, measuring or recording for evaluating the integumentary system, e.g. skin, hair or nails
- A61B5/441—Skin evaluation, e.g. for skin disorder diagnosis
-
- G—PHYSICS
- G01—MEASURING; TESTING
- G01B—MEASURING LENGTH, THICKNESS OR SIMILAR LINEAR DIMENSIONS; MEASURING ANGLES; MEASURING AREAS; MEASURING IRREGULARITIES OF SURFACES OR CONTOURS
- G01B9/00—Measuring instruments characterised by the use of optical techniques
- G01B9/02—Interferometers
- G01B9/02055—Reduction or prevention of errors; Testing; Calibration
- G01B9/02062—Active error reduction, i.e. varying with time
- G01B9/02067—Active error reduction, i.e. varying with time by electronic control systems, i.e. using feedback acting on optics or light
-
- G—PHYSICS
- G01—MEASURING; TESTING
- G01B—MEASURING LENGTH, THICKNESS OR SIMILAR LINEAR DIMENSIONS; MEASURING ANGLES; MEASURING AREAS; MEASURING IRREGULARITIES OF SURFACES OR CONTOURS
- G01B9/00—Measuring instruments characterised by the use of optical techniques
- G01B9/02—Interferometers
- G01B9/0209—Low-coherence interferometers
- G01B9/02091—Tomographic interferometers, e.g. based on optical coherence
-
- A—HUMAN NECESSITIES
- A61—MEDICAL OR VETERINARY SCIENCE; HYGIENE
- A61B—DIAGNOSIS; SURGERY; IDENTIFICATION
- A61B5/00—Measuring for diagnostic purposes; Identification of persons
- A61B5/0059—Measuring for diagnostic purposes; Identification of persons using light, e.g. diagnosis by transillumination, diascopy, fluorescence
Definitions
- the present invention relates to an imaging device using optical coherence tomography, an imaging method, and medical equipment used in observing, for example, the fundus of an eye or skin.
- an imaging device hereunder may also be referred to as an "OCT device" using optical coherence tomography (OCT) making use of coherence of low coherence light has been put into practical use. Since it is possible to obtain a tomographic image at a resolution of an order of a wavelength of light that is incident upon a sample, the tomographic image of the sample can be obtained with high resolution.
- the OCT device in obtaining a tomographic image of a fundus/retina in the ophthalmologic field, the OCT device is becoming an indispensible device. Even outside the ophthalmologic field, tomographic observation of the skin and tomographic imaging operation of a wall of a circulatory organ or a digestive organ using the OCT device as an endoscope or a catheter are carried out.
- TD-OCT time domain-OCT
- FD-OCT Fourier domain-OCT
- the FD-OCT is a method in which spectrum information of interference light is subjected to Fourier transformation, to obtain together pieces of intensity information corresponding to depth-direction positions. Therefore, the FD-OCT can obtain a tomographic image at a higher speed than the TD-OCT in which a coherence gate position is changed for obtaining a depth-direction position.
- the OCT device when making measurements at a high resolution, a measurement area per beam becomes narrow, as a result of which a relatively large amount of measurement time is required.
- imaging operations are required to be performed at high speeds. This is because images may be displaced from each other by, for example, involuntary eye movement during the imaging operation.
- Patent Literature 1 discusses a method that uses a plurality of beams and that narrows a measurement area per one beam to reduce the measurement time.
- an interferometer that separates nine beams into measuring lights and reference lights is used. Interference lights obtained from the respective beams are dispersed, and the dispersed interference lights are detected with the same two-dimensional sensor array for the plurality of beams.
- light generated from the light source generates light having wavelength widths that are larger than an intended wavelength width.
- the distances between areas where the respective interference lights are detected are made sufficiently large. This is because, when the plurality of interference lights are superimposed upon each other on the sensor, crosstalk occurs between the interference lights, thereby generating noise in a resulting tomographic image that is obtained.
- An imaging device includes an illuminating section configured to illuminate an examination object with first and second measuring lights; a detecting section configured to detect a first combined light based on the first measuring light and a second combined light based on the second measuring light; a reducing section configured to reduce superimposition of the first and second combined lights upon each other at the detecting section; and an obtaining section configured to obtain an optical coherence tomographic image of the examination object based on the first and second combined lights whose superimposition has been reduced at the reducing section.
- An imaging method includes the steps of illuminating different positions of an examination object with measuring lights formed of a plurality of lights; combining returning lights and reference lights formed of a plurality of lights, the returning lights corresponding to the measuring lights, formed of the plurality of lights, that are reflected or scattered by the examination object; detecting interference lights, formed by the combining of the returning lights and the reference lights, with a sensor; reducing a light quantity of a portion where a first interference light and a second interference light adjacent to the first interference light are superimposed upon each other at the sensor that receives the interference lights; and obtaining an optical coherence tomographic image of the examination object.
- the light quantity resulting from the plurality of dispersed lights being superimposed upon each other at a sensor is reduced. By this, it is possible to prevent crosstalk from occurring between the dispersed lights on the sensor. In addition, it is possible to bring areas (unit: pixels) where the plurality of lights illuminate the sensor towards each other.
- Fig. 1A is schematic view illustrating, for example, the structure of an imaging device using optical coherence tomography according to a first embodiment.
- Fig. 1B is schematic view illustrating, for example, the structure of the imaging device using optical coherence tomography according to the first embodiment.
- Fig. 1C is schematic view illustrating, for example, the structure of the imaging device using optical coherence tomography according to the first embodiment.
- Fig. 2A is a schematic view of interference signal spectra according to the first embodiment.
- Fig. 2B is a schematic view of interference signal spectra when an optical filter is not provided.
- Fig. 2C is a schematic view of interference signal spectra according to a third embodiment.
- Fig. 3A shows an interference-signal wavelength spectrum according to the first embodiment.
- Fig. 3B shows an interference-signal wavelength spectrum according to the first embodiment.
- Fig. 3C shows an interference-signal wavelength spectrum according to the first embodiment.
- Fig. 3D shows a wavelength spectrum when an optical filter is not provided.
- Fig. 4A shows an OCT image according to the first embodiment.
- Fig. 4B shows the OCT image according to the first embodiment.
- Fig. 4C shows the OCT image according to the first embodiment.
- Fig. 4D shows an OCT image when an optical filter is not provided.
- Fig. 5A is a schematic view illustrating the structure of an imaging device using optical coherence tomography according to a second embodiment.
- Fig. 5B is a schematic view illustrating the structure of an imaging device using optical coherence tomography according to a third embodiment.
- Fig. 5A is a schematic view illustrating the structure of an imaging device using optical coherence tomography according to a second embodiment.
- Fig. 5B is a schematic view illustrating the
- FIG. 6A is a schematic view illustrating the structure of an imaging device using optical coherence tomography according to a fourth embodiment.
- Fig. 6B is a schematic view illustrating the structure of the imaging device using optical coherence tomography according to the fourth embodiment.
- Fig. 7A is a schematic view illustrating the structure of an imaging device using optical coherence tomography according to a fifth embodiment.
- Fig. 7B is a schematic view illustrating the structure of the imaging device using optical coherence tomography according to the fifth embodiment.
- An imaging device (which may also be called an "imaging device using optical coherence tomography") according to an embodiment of the present invention will be described with reference to Figs. 1A and 1B.
- reference numeral 101 denotes a light source for generating light (low coherence light).
- a super luminescent diode (SLD) can be applied to the light source 101.
- Amplified spontaneous emission (ASE) can also be applied to the light source 101.
- ultrashort pulse laser such as titanium sapphire laser, can also be applied to the light source 101. Anything that can generate low coherence light may be applied to the light source 101.
- the wavelength of the light generated from the light source 101 though not particularly limited, is in the range of from 400 nm to 2 [micro]m.
- a wavelength interval for realizing OCT may be, for example, 1 nm or more; desirably, 10 nm or more; and, more desirably, 30 nm or more.
- Reference numerals 103 denote splitting sections that split the light from the light source 101 into reference lights and measuring lights.
- a beam splitter or a fiber coupler may be applied to the splitting sections 103.
- anything that can split the light may be applied to the splitting sections 103.
- Reference numeral 105 denotes a scanning optical section (which may also be called a "scanning section") for scanning an examination object to be examined 120 with the measuring lights.
- a scanning optical section which may also be called a "scanning section"
- a galvano scanner is desirably used for the scanning optical section 105.
- anything that can scan an examination object with light may be used.
- Reference numeral 110 denotes a detecting section (spectroscope) for detecting combined lights of the reference lights and returning lights from the examination object 120.
- the detecting section 110 includes a dispersing element 114 (which may also be called a "dispersing section") for dispersing a plurality of combined lights (117a, 117b, 117c).
- the dispersing element 114 is, for example, a diffraction grating or a prism, and may be anything that can disperse the light.
- the detecting section 110 includes a sensor 116 for detecting a plurality of dispersed lights (118a, 118b, 118c) dispersed by the dispersing element 114.
- the sensor 116 may be a line sensor, a two-dimensional sensor, or anything that can detect the light.
- the examination object 120 can be scanned with the plurality of measuring lights used to scan the examination object 120.
- the method that a Michelson type interferometer uses for forming a plurality of measuring lights differs from the method that a Mach-Zehnder type interferometer uses for forming a plurality of measuring lights (described later).
- the sensor 116 has first and second areas (for example, areas 119a, 119b, 119c) where first and second lights that have been dispersed (for example, lights 118a, 118b, 118c) are focused.
- first and second areas refer to areas (unit: pixels) where the sensor is irradiated with the plurality of dispersed lights.
- 1170 pixels where the dispersed lights are focused correspond to the first and second areas.
- the device is formed so that, of the first lights (such as the light 118a), the quantity of light having a wavelength that can illuminate the second area (such as the area 119b) is reduced (that is, the light is intercepted or the light quantity is reduced).
- the device is formed so that the light quantity resulting from the plurality of dispersed lights being superimposed upon each other on the sensor 116 is reduced.
- the first and second areas can be brought as close as possible to each other. That is, the distances between the first and second areas (unit: pixels) can be made small (the number of pixels can be made small). This includes a state in which the distance is zero.
- 132 pixels, provided between the first and second areas formed by the 1170 pixels, correspond to the distance.
- the imaging device includes an irradiating section (such as the scanning section) configured to irradiate an examination object with the first and second measuring lights.
- the imaging device also includes a detecting section (such as the dispersing section) that detects first combined lights, which are based on first measuring lights, and second combined lights, which are based on second measuring lights.
- the first combined lights are formed by combining returning lights (returning from the examination object irradiated with the first measuring lights) with first reference lights corresponding to first measuring lights.
- the second combined lights are formed by combining returning lights (returning from the examination object irradiated with the second measuring lights) with second reference lights corresponding to second measuring lights.
- the imaging device includes a reducing section (such as an optical filter (described later)) that reduces the amount by which the first and second combined lights are superimposed upon each other at the detecting section.
- the imaging device includes an obtaining section (not shown) that obtains an optical coherence tomographic image (which may also be called a "tomographic image") based on the first and second combined lights whose superposition amount has been reduced at the reducing section. Anything may be used for the obtaining section as long as it obtains a tomographic image by performing a signal processing operation such as Fourier transformation on data transmitted from the sensor of the detecting section.
- the imaging device include a light-quantity reducing member (which may also be called a "reducing section") for reducing the superposition amount.
- a light-quantity reducing member (which may also be called a "reducing section") for reducing the superposition amount.
- the light-quantity reducing member it is desirable to use an optical filter 112 that is capable of limiting transmittance or reflectivity of light having a particular wavelength.
- the optical filter 112 reduces the superposition amount of the plurality of combined lights (117a, 117b, 117c).
- the plurality of combined lights whose superposition amount has been reduced are dispersed by the dispersing element 114.
- an intercepting member 410 that intercepts the plurality of the dispersed lights (118a, 118b, 118c).
- the device be formed so that the plurality of dispersed lights (118a, 118b, 118c) are focused on the respective areas (119a, 119b, 119c).
- the splitting sections 103 are formed so that the reference lights and the measuring lights are combined. That is, the splitting sections 103 are formed so as to split the light generated from the light source 101 into reference lights and measuring lights, and so as to combine the reference lights and returning lights.
- the splitting sections 103 split the light generated from the light source 101 into a plurality of lights, and split the plurality of split lights into reference lights and measuring lights (first and second embodiments).
- Light is generated from a plurality of the light sources 910a, 910b, and 910c. Then, the plurality of lights are split into reference lights and measuring lights (third embodiment in which a plurality of light sources are provided).
- a combining section for combining the reference lights and the measuring lights is provided.
- the combining section is, for example, a fiber coupler 407 or anything else that can combine the lights.
- Light generated from the light source 101 is split into the measuring lights and the reference lights, and the split measuring lights and the split reference lights are split into a plurality of lights.
- An imaging method using optical coherence tomography includes the following steps: a) illuminating different positions of an examination object with measuring lights formed of a plurality of lights; b) combining returning lights and reference lights formed of a plurality of lights, the returning lights corresponding to the measuring lights, formed of the plurality of lights, that are reflected or scattered by the examination object; c) detecting interference lights, formed by the combining of the returning lights and the reference lights, with a sensor; d) reducing a light quantity of a portion where a first interference light and a second interference light adjacent to the first interference light are superimposed upon each other at the sensor that receives the interference lights; and e) obtaining a tomographic image (may also be called a "optical coherence tomographic image" of the examination object.
- the imaging method using optical coherence tomography may be stored in a computer-readable storage medium (such as a flexible disc, a hard disk, an optical disk, a magneto-optical disk, a CD-ROM, a CD-R, a magnetic tape, a nonvolatile memory card, ROM, EEPROM, or Blu-ray Disc) as a program to be executed by a computer.
- a computer-readable storage medium such as a flexible disc, a hard disk, an optical disk, a magneto-optical disk, a CD-ROM, a CD-R, a magnetic tape, a nonvolatile memory card, ROM, EEPROM, or Blu-ray Disc
- a still another embodiment may be related to a program for executing by a computer the aforementioned method using optical coherence tomography.
- a fiber beam splitter 102 splits light that has exited from a low-coherence light source 101 into a plurality of lights.
- Fiber couplers 103 further split the plurality of split lights into measuring lights and reference lights formed by the plurality of lights. Then, as mentioned below, the measuring lights are guided to an examination object (which is a measurement object), and the reference lights are guided to a reference mirror. When the measuring lights, formed by the plurality of lights, are guided to the examination object, the measuring lights are emitted from fiber collimators 104 that are arranged at a particular interval.
- the measuring lights formed by the plurality of lights, used for scanning by a scanning unit (a scanning optical system) 105 for beam scanning illuminate a measurement object (examination object) 120 through an objective lens 106 constituting an illumination optical system.
- Returning lights formed by reflection or scattering of the measuring lights at the measurement object 120, pass through the same optical system again and return to the fiber couplers 103.
- the reference lights exit from fiber collimators 107, are reflected by a reference mirror 109, and return to the fiber couplers 103.
- the reference lights pass through a dispersion compensation glass.
- the measuring lights that have been scattered by the measurement object 120 and that have returned to the fiber couplers 103 and the reference lights that have been reflected by the reference mirror 109 and that have returned to the fiber couplers 103 are combined with each other at the fiber couplers 103, so that interference lights are formed.
- the interference lights, formed by combining the measuring lights and the reference lights at the fiber couplers 103 in this way, are detected as interference signals corresponding to the respective measuring lights by an interference-light detecting device 110.
- the interference-light detecting device 110 has the structure shown in Fig. 1B.
- the interference lights input by the fibers exit into the air from fiber ends 111 arranged at a particular interval, pass through an optical filter 112 (that passes only light having wavelengths of a particular wavelength range), and are formed into parallel lights by a collimator lens 113.
- the parallel lights pass through a dispersing element 114 (such as a prism or a diffraction grating), and are dispersed, that is, are subjected to wavelength separation. Then, the dispersed lights are focused on a sensor array 116 by a focusing lens 115.
- the input interference lights 117a, 117b, and 117c are dispersed, and are focused for respective wavelengths at different areas on the sensor array 116.
- a transmission wavelength band of the optical filter 112 is set so that the interference lights that are adjacent to each other are not superimposed upon each other (that is, so that crosstalk does not occur). That is, a portion of a long-wavelength-side light of one of the adjacent interference lights and a portion of a short-wavelength-side light of the other adjacent interference light are prevented from passing through the optical filter 112. Therefore, it is possible to efficiently obtain a plurality of interference signals without crosstalk.
- Data obtained at the sensor array 16 is subjected to a signal processing step including a Fourrier transformation operation, and is converted into OCT data.
- adjacent interference lights can be disposed next to each other on the sensor array without crosstalk. Therefore, interference signals corresponding to a plurality of beams can be detected using a minimum number of sensor array pixels. Consequently, an OCT device that can obtain signals at a high speed can be easily provided.
- An imaging device is Michelson type interferometer.
- optical filter is disposed at location where light has not yet been dispersed.
- the imaging device using optical coherence tomography shown in Fig. 1A will be used.
- the retina of an eye is an examination object 120 used as a measurement object.
- the low-coherence light source 101 an SLD light source having an output of 20 mW, a center wavelength of 840 nm and a wavelength width of 45 nm is used.
- Light emitted from the SLD light source 101 is equally split into three lights by a 1-to-3 fiber beam splitter 102.
- the lights are branched into measuring lights and reference lights by three 50:50 fiber couplers 103.
- the measuring lights are formed into parallel beams by three fiber collimators 104.
- a scanning optical system 105 formed by a galvano scanner and a scan lens
- the objective lens 106 serving as an illumination optical system
- the retina 120 of the eye is irradiated with the parallel beams.
- the beams are set so as to scan three different positions 201a, 201b, and 201c of the fundus 200.
- Returning lights, formed by reflection or scattering of the lights by the retina 120 pass through the same optical system again, and return to the fiber couplers 103.
- the reference lights pass through a BK7 glass 108.
- the measuring lights that have been scattered by the retina 120 and that have returned to the fiber couplers 103 and the reference lights that have been reflected by the reference mirror 109 and that have returned to the fiber couplers 103 are combined with each other at the fiber couplers 103, so that interference lights are formed.
- a spectroscope 110 which is an interference-signal detecting device, disperses and detects the interference lights for respective wavelengths.
- the spectroscope 110 has the structure shown in Fig. 1B.
- the interference lights input by the fibers exit into the air from fiber ends 111 arranged at a certain interval, pass through a band-pass filter 112 (that passes only light having wavelengths in a wavelength range of from 810 nm to 870 nm, that is, light within a wavelength width of 60 nm), and are formed into parallel lights by a collimator lens 113.
- the parallel lights are dispersed by a 1200/mm transmission diffraction element 114, and are focused on a line sensor 116 having a pixel size of 10 [micro]m, having 4096 pixels, and having a line read-out period of 70 kHz by a focusing lens 115.
- Lenses in the spectroscope are selected so that the wavelengths of 810 nm to 870 nm are dispersed for 1170 pixels of the line sensor.
- graphs in a schematic view shown in Fig. 2A are generated.
- the interference signals are schematically drawn with simple lines while ignoring signals of small periods of the interference signals.
- lights having wavelengths in the range of from 810 nm to 870 nm illuminate the line sensor and are detected by the line sensor.
- the wavelength spectra of the interference signals 117a, 117b, and 117c corresponding to the three measurement beams 201a, 201b, and 201c is measured.
- signal processing including a Fourrier transformation processing operation is performed on the basis of data of the measurement, three OCT images are obtained as shown in Fig. 4.
- the wavelength spectra of the interference signals detected by the spectroscope are such that crosstalk occurs between adjacent beams as shown in Fig. 2B.
- the interference signals in this state are as shown in Fig. 3D.
- Signal intensity at the right end of Fig. 3D is larger than signal intensities at the right ends of Figs. 3A to 3C. This is caused by the influence of crosstalk.
- the interference signals, which influence the crosstalk are converted into OCT images, as shown in Fig. 4D, an unclear image that is superimposed by a portion of another beam image as a noise component is formed.
- OCT images formed by a plurality of beams, are such that measuring signals for forming tomographic images having reduced noise components can be obtained at a high speed with a sensor array having a minimum number of pixels.
- the plurality of interference lights can be brought close to each other so as not to be superimposed upon each other on the sensor and so that noise components do not stand out when the interference lights are displayed as tomographic images.
- the structure in which the band-pass filter 112 is inserted as the optical filter is described, similar effects can be provided if optical filters that limit the wavelengths of light reaching the line sensor 116 are used.
- a short-pass filter that passes only short wavelengths a long-pass filter that passes only long wavelengths, or a notch filter that does not pass particular wavelengths may also be used.
- any combination of these optical filters may be used.
- methods of producing the optical filter any method that is not an absorption type, a reflecting type, or an interference type based on a dielectric multilayer film may be used.
- the optical filter 112 when the optical filter is disposed in the spectroscope, the optical system can be reduced in size.
- An imaging device is Michelson Type Interferometer.
- optical filter is disposed at location where light has not yet been split into reference lights and measuring lights.
- a structure in which the position of the optical filter 112 is changed by using a bulk optical system is used instead of the optical fiber in the imaging device using optical coherence tomography in the first embodiment.
- Fig. 5A illustrates the structure of an imaging device using optical coherence tomography to which a bulk optical system is applied according to the second embodiment.
- component parts having the same structures as those of the component parts shown in Fig. 1A are given the same reference numerals, so that common portions will not be described below.
- reference numeral 903 denotes a collimate lens array
- reference numeral 904 denotes a cube beam splitter
- reference numeral 905 denotes an illumination optical system
- reference numeral 906 denotes a dispersion compensation glass
- reference numeral 907 denotes a reference mirror
- reference numeral 908 denotes an interference-signal detecting device.
- an optical system that is provided at a location where light from a light source has already been equally split into three beams by a 1-to-3 fiber beam splitter 102 is formed by a bulk optical system.
- the collimate lens array 903 collimates the beams into parallel beams.
- the three beams pass through a band-pass filter 112, and is split into measuring lights and reference lights by the 50:50 cube beam splitter 904.
- the three measuring lights are focused on a retina 120 by the illumination optical system including an eyepiece, a galvano scanner, and a scan lens.
- the three beams are adjusted so as to scan portions represented by line segments and the respective beam spots 201a, 201b, and 201c shown in Fig. 1C.
- Lights that are scattered from a focusing point of the three beams are guided to the cube beam splitter 904 through the illumination optical system 905, and are combined with the reference lights.
- the reference lights pass through the dispersion compensation glass 906, are reflected by the reference mirror 907, and return to the cube beam splitter 904.
- the reference lights and the measuring lights that have returned to the cube beam splitter 904 are combined, and become interference lights.
- the interference lights are guided to the interference-signal detecting device 908.
- the interference-signal detecting device 908 has a structure corresponding to that of the spectroscope shown in Fig. 1A that does not include the band-pass filter 112. Even in the structure according to this embodiment, the advantages of the band-pass filter 112 are provided, so that, as in Fig. 2A, there is no crosstalk between interference signals detected by a line sensor 116.
- the optical filter 112 for limiting the wavelengths of the lights reaching the line sensor 116 such as a band-pass filter
- the line sensor 116 such as a band-pass filter
- An imaging device is Michelson Type Interferometer.
- different optical filters are disposed for respective beams.
- a structure in which separate light sources are provided for respective beams is described instead of the structure in which one low-coherence light source 101 branches light into a plurality of beams as in the imaging device making use of optical coherence tomography according to the first and second embodiments.
- Fig. 5B illustrates the structure of an imaging device using optical coherence tomography to which a bulk optical system is applied according to the third embodiment.
- component parts having the same structures as those of the component parts shown in Fig. 1A are given the same reference numerals, so that common portions will not be described below.
- reference numerals 910a, 910b, and 910c denote low-coherence light sources
- reference numeral 911 denotes a fiber collimator array
- reference numerals 912a, 912b, and 912c denote optical filters.
- the low-coherence light sources 910a, 910b, and 910c corresponding to beams 201a, 201b, and 201c that scan a retina are provided.
- the structure of the imaging device according to the third embodiment is the same as that of the imaging device using optical coherence tomography to which a bulk optical system is applied according to the second embodiment except that lights from the respective light sources are collimated into parallel beams by the fiber collimator array 911 and that the parallel lights pass through the respective optical filters 912a, 912b, and 912c.
- Fig. 2C is a schematic view of wavelength spectra of interference signals corresponding to the respective beams in the embodiment.
- the shapes of the wavelength spectra of the respective light sources differ from each other due to manufacturing spread.
- SLD light sources having an output of 20 mW, a center wavelength of 840 nm and a wavelength width of 45 nm are used.
- the optical filter 912a is a long-pass filter that passes wavelengths greater than or equal to 810 nm therethrough.
- the optical filter 912b is a band-pass filter that passes wavelengths of from 810 nm to 870 nm therethrough.
- the optical filter 912c is a short-pass filter that passes wavelengths less than or equal to 870 nm therethrough.
- Fig. 2C it is possible to obtain wavelength spectra that do not include crosstalk, and, as in the first and second embodiments, to obtain at a high speed OCT images by a plurality of beams with a sensor array having a minimum number of pixels.
- the present invention is effective for any case in which two or more measuring beams are used.
- a one-dimensional line sensor is exemplified as a sensor array that detects interference signal spectra, similar advantages are also obtained when a two-dimensional sensor array or a plurality of sensor arrays are used.
- An imaging device is Mach-Zehnder Type Interferometer.
- intercepting member is disposed at a location where light has already been dispersed.
- Figs. 6A and 6B are schematic views illustrating the structure of an imaging device using optical coherence tomography to which a Mach-Zehnder type interferometer is applied according to the fourth embodiment.
- component parts having the same structures as those of the component parts shown in Fig. 1A and 1B are given the same reference numerals, so that common portions will not be described below.
- Light generated from an SLD light source 101 is branched into measuring light and reference light by a 1-to-2 fiber beam splitter 401.
- the measuring light is equally split in three by a 1-to-3 fiber beam splitter 102, and the three beams are input to respective optical circulators 402.
- the lights that have passed through the respective optical circulators 402 are collimated into parallel beams by three fiber collimators 104.
- an objective lens 106 and an illumination optical system 105 including a galvano scanner and a scan lens cause the parallel lights to illuminate a retina 120 of an eye.
- the lights that have returned to the optical circulators 402 are output to 2-to-1 fiber couplers 407 instead of to the fiber beam splitter 102.
- the reference lights pass through an optical circulator 403, exit from a fiber collimator 404, pass through a dispersion compensation glass 405, is reflected by a reference mirror 109, and returns to the optical circulator 403.
- the reflected light that has returned to the optical circulator 403 is output to a 1-to-3 fiber beam splitter 406 by the optical circulator 403, and is equally split in three.
- the split lights are input to 2-to-1 fiber couplers 407.
- a spectroscope 400 serving as an interference-signal detecting device, disperses and detects the interference lights for respective wavelengths.
- the spectroscope 400 has the structure shown in Fig. 6B.
- the structure of the spectroscope 400 is the same as that of the spectroscope 110 in the first embodiment except that an aperture 410 is inserted behind a transmission diffraction grating 114.
- the aperture 410 has a circular hole formed in an aluminum plate subjected to black alumite treatment. Light that has passed through the transmission diffraction grating 114 exits from the transmission diffraction grating 114 at angles that differ for respective wavelengths.
- the size of the circular hole of the aperture 410 is adjusted so that light having wavelengths less than or equal 810 nm and light having wavelengths greater than or equal to 870 nm are intercepted. Therefore, as in Figs.
- wavelength spectra of interference signals 117a, 117b, and 117c are measured.
- signal processing including a Fourrier transformation processing operation is performed on the basis of data thereof, three OCT image are obtained as shown in Fig. 4.
- an aluminum plate subjected to black alumite treatment is used as the aperture, as long as members that do not pass predetermined lights, such as those made of metal, wood, or paper, are used, the advantages of the present invention can be provided.
- the optical filter 112 may be used instead of the aperture 410.
- the aperture 410 may be used instead of the optical filter 112.
- the advantages of the present invention can be provided regardless of the form of an interferometer or even when, instead of an optical filter, a light intercepting member is used as an adjusting member for adjusting light quantity.
- Figs. 7A and 7B are schematic views illustrating the structure of an imaging device using optical coherence tomography in which an optical filter is disposed in a reference-light optical path according to the fifth embodiment.
- Figs. 7A and 7B component parts having the same structures as those of the component parts shown in Figs. 1A and 1B and Figs. 6A and 6B are given the same reference numerals, so that common portions will not be described below.
- the imaging device shown in Fig. 7 differs from that in Fig. 6 in that an optical filter 112 is disposed in a reference-light optical path and in that a spectroscope 500 has a different structure.
- the optical filter 112 has the same characteristics as those of the optical filter 112 described in the first embodiment.
- the spectroscope 500 has a structure corresponding to the spectroscope 110 described in the first embodiment that does not include the optical filter 112.
- the optical filter 112 does not influence measuring lights and returning lights. Therefore, lights other than those having wavelengths of from 810 nm to 870 nm included in returning lights returning from a retina 120 of an eye are mixed in combined lights at fiber couplers 407.
- the reflectivity at the retina 120 of the eye is approximately 0.001% (-50 dB), so that the light quantity of the lights having such wavelengths can be ignored with respect to the light quantity of reference lights. Therefore, since the amount of crosstalk on a line sensor 116 can be essentially ignored, it is possible to bring the plurality of interference lights close to each other on the sensor so as to prevent them from being superimposed upon each other to the extent possible.
- the optical filter 112 By providing the optical filter 112 in the optical path of reference lights, the returning light quantity is not lost by the optical filter. Therefore, since the returning lights are efficiently used in the combined lights, it is possible to obtain a relatively high quality tomographic image.
- the advantages of the present invention are obtained.
- a Mach-Zehnder type interferometer is used as an example, a similar structure is possible even for other types of interferometers such as a Michelson type interferometer.
- aspects of the present invention can also be realized by a computer of a system or apparatus (or devices such as a CPU or MPU) that reads out and executes a program recorded on a memory device to perform the functions of the above-described embodiment(s), and by a method, the steps of which are performed by a computer of a system or apparatus by, for example, reading out and executing a program recorded on a memory device to perform the functions of the above-described embodiment(s).
- the program is provided to the computer for example via a network or from a recording medium of various types serving as the memory device (e.g., computer-readable medium).
Landscapes
- Health & Medical Sciences (AREA)
- Life Sciences & Earth Sciences (AREA)
- Physics & Mathematics (AREA)
- General Health & Medical Sciences (AREA)
- Engineering & Computer Science (AREA)
- Public Health (AREA)
- Veterinary Medicine (AREA)
- Biomedical Technology (AREA)
- Heart & Thoracic Surgery (AREA)
- Medical Informatics (AREA)
- Molecular Biology (AREA)
- Surgery (AREA)
- Animal Behavior & Ethology (AREA)
- Biophysics (AREA)
- Pathology (AREA)
- Nuclear Medicine, Radiotherapy & Molecular Imaging (AREA)
- Radiology & Medical Imaging (AREA)
- Ophthalmology & Optometry (AREA)
- General Physics & Mathematics (AREA)
- Dermatology (AREA)
- Spectroscopy & Molecular Physics (AREA)
- Automation & Control Theory (AREA)
- Optics & Photonics (AREA)
- Chemical & Material Sciences (AREA)
- Immunology (AREA)
- Biochemistry (AREA)
- Analytical Chemistry (AREA)
- Investigating Or Analysing Materials By Optical Means (AREA)
- Measurement Of The Respiration, Hearing Ability, Form, And Blood Characteristics Of Living Organisms (AREA)
- Eye Examination Apparatus (AREA)
Priority Applications (4)
| Application Number | Priority Date | Filing Date | Title |
|---|---|---|---|
| US13/320,740 US8836951B2 (en) | 2009-05-22 | 2010-05-20 | Imaging device for optical coherence tomographic image and imaging method |
| CN201080022514.7A CN102438501B (zh) | 2009-05-22 | 2010-05-20 | 摄像装置和摄像方法 |
| KR1020117030118A KR101380690B1 (ko) | 2009-05-22 | 2010-05-20 | 촬상 장치 및 촬상 방법 |
| EP10725888A EP2432374A1 (en) | 2009-05-22 | 2010-05-20 | Imaging device and imaging method |
Applications Claiming Priority (4)
| Application Number | Priority Date | Filing Date | Title |
|---|---|---|---|
| JP2009-124273 | 2009-05-22 | ||
| JP2009124273 | 2009-05-22 | ||
| JP2010066729A JP5627259B2 (ja) | 2009-05-22 | 2010-03-23 | 撮像装置及び撮像方法 |
| JP2010-066729 | 2010-03-23 |
Publications (2)
| Publication Number | Publication Date |
|---|---|
| WO2010134342A1 true WO2010134342A1 (en) | 2010-11-25 |
| WO2010134342A4 WO2010134342A4 (en) | 2011-03-17 |
Family
ID=42562601
Family Applications (1)
| Application Number | Title | Priority Date | Filing Date |
|---|---|---|---|
| PCT/JP2010/003384 Ceased WO2010134342A1 (en) | 2009-05-22 | 2010-05-20 | Imaging device and imaging method |
Country Status (6)
| Country | Link |
|---|---|
| US (1) | US8836951B2 (enExample) |
| EP (1) | EP2432374A1 (enExample) |
| JP (1) | JP5627259B2 (enExample) |
| KR (1) | KR101380690B1 (enExample) |
| CN (1) | CN102438501B (enExample) |
| WO (1) | WO2010134342A1 (enExample) |
Cited By (2)
| Publication number | Priority date | Publication date | Assignee | Title |
|---|---|---|---|---|
| US20120194661A1 (en) * | 2010-12-24 | 2012-08-02 | Gwangju Institute Of Science And Technology | Endscopic spectral domain optical coherence tomography system based on optical coherent fiber bundle |
| US20150351669A1 (en) * | 2013-01-22 | 2015-12-10 | Becton, Dickinson And Company | Reduced Size Optical Coupler for Fluorescence Detection |
Families Citing this family (16)
| Publication number | Priority date | Publication date | Assignee | Title |
|---|---|---|---|---|
| JP3125389B2 (ja) | 1991-12-25 | 2001-01-15 | 大日本印刷株式会社 | 樹脂成形品の製造方法 |
| JP5331904B2 (ja) * | 2011-04-15 | 2013-10-30 | 富士フイルム株式会社 | 内視鏡システム及び内視鏡システムの作動方法 |
| JP6281177B2 (ja) * | 2013-01-23 | 2018-02-21 | 株式会社ニデック | 眼科撮影装置 |
| EP3042600A1 (en) | 2013-09-03 | 2016-07-13 | Olympus Corporation | Optical measurement device |
| KR101488115B1 (ko) * | 2013-12-30 | 2015-01-29 | 건양대학교산학협력단 | 초소형 방사선 컴퓨터 단층촬영장치 |
| GB2540390A (en) * | 2015-07-15 | 2017-01-18 | Michelson Diagnostics Ltd | Processing optical coherency tomography scans |
| US9869541B2 (en) * | 2015-07-22 | 2018-01-16 | Medlumics S.L. | High-speed optical coherence tomography using multiple interferometers with suppressed multiple scattering cross-talk |
| US10323926B2 (en) * | 2017-06-21 | 2019-06-18 | Canon U.S.A., Inc. | Crosstalk elimination or mitigation in optical coherence tomography |
| JP6908131B2 (ja) | 2017-12-25 | 2021-07-21 | 日本電気株式会社 | 光ビーム制御器およびこれを用いた光干渉断層撮像器 |
| CN108514404B (zh) * | 2018-03-28 | 2021-08-10 | 深圳市太赫兹科技创新研究院 | 光学相干断层成像系统 |
| KR101990251B1 (ko) * | 2018-10-15 | 2019-06-17 | 경북대학교 산학협력단 | 광 간섭성 단층 촬영 장치 및 이를 이용한 영상 생성 방법 |
| CN109620134B (zh) * | 2019-01-21 | 2020-05-22 | 浙江大学 | 基于光纤阵列多通道并行探测的微血管造影方法和系统 |
| CN114076746A (zh) * | 2020-08-20 | 2022-02-22 | 株式会社湖碧驰 | 利用双线条相机的断层摄影检查装置和方法 |
| KR102498742B1 (ko) * | 2021-05-11 | 2023-02-13 | 경북대학교 산학협력단 | 초점 심도 향상을 위한 다중 초점 기반 고해상도 광간섭 단층 촬영 장치 |
| JP2024061609A (ja) * | 2022-10-21 | 2024-05-07 | ツー-シックス デラウェア インコーポレイテッド | レーザー材料加工工程における光コヒーレンス断層撮影のためのデバイスおよび方法 |
| KR102881516B1 (ko) * | 2025-01-20 | 2025-11-05 | 한국전광(주) | 대면적 시료용 고속 스웹 소스 광간섭 단층촬영장치 |
Citations (2)
| Publication number | Priority date | Publication date | Assignee | Title |
|---|---|---|---|---|
| WO2006015717A1 (de) * | 2004-08-03 | 2006-02-16 | Carl Zeiss Meditec Ag | Fourier-domain oct ray-tracing am auge |
| WO2006054116A2 (en) * | 2004-11-18 | 2006-05-26 | Michelson Diagnostics Limited | Interference apparatus and method and probe |
Family Cites Families (6)
| Publication number | Priority date | Publication date | Assignee | Title |
|---|---|---|---|---|
| JPH07143281A (ja) * | 1993-11-15 | 1995-06-02 | Fuji Xerox Co Ltd | カラー画像読取装置 |
| US7263394B2 (en) * | 2003-06-04 | 2007-08-28 | Tomophase Corporation | Coherence-gated optical glucose monitor |
| US7671992B2 (en) * | 2004-10-28 | 2010-03-02 | X-Rite Europe Gmbh | Measurement system and scanning device for the photoelectric measurement of a measurement object pixel by pixel |
| WO2008089393A2 (en) | 2007-01-19 | 2008-07-24 | Thorlabs, Inc. | An optical coherence tomography imaging system and method |
| US8948846B2 (en) * | 2007-09-19 | 2015-02-03 | The Research Foundation Of State University Of New York | Optical coherence tomography systems and methods |
| JP5576367B2 (ja) * | 2008-07-16 | 2014-08-20 | カール ツアイス メディテック アクチエンゲゼルシャフト | 光コヒーレンストモグラフィ方法およびシステム |
-
2010
- 2010-03-23 JP JP2010066729A patent/JP5627259B2/ja not_active Expired - Fee Related
- 2010-05-20 KR KR1020117030118A patent/KR101380690B1/ko not_active Expired - Fee Related
- 2010-05-20 EP EP10725888A patent/EP2432374A1/en not_active Withdrawn
- 2010-05-20 CN CN201080022514.7A patent/CN102438501B/zh not_active Expired - Fee Related
- 2010-05-20 US US13/320,740 patent/US8836951B2/en not_active Expired - Fee Related
- 2010-05-20 WO PCT/JP2010/003384 patent/WO2010134342A1/en not_active Ceased
Patent Citations (3)
| Publication number | Priority date | Publication date | Assignee | Title |
|---|---|---|---|---|
| WO2006015717A1 (de) * | 2004-08-03 | 2006-02-16 | Carl Zeiss Meditec Ag | Fourier-domain oct ray-tracing am auge |
| JP2008508068A (ja) | 2004-08-03 | 2008-03-21 | カール ツァイス メディテック アクチエンゲゼルシャフト | 眼のフーリエ領域octレイ・トレーシング法 |
| WO2006054116A2 (en) * | 2004-11-18 | 2006-05-26 | Michelson Diagnostics Limited | Interference apparatus and method and probe |
Cited By (3)
| Publication number | Priority date | Publication date | Assignee | Title |
|---|---|---|---|---|
| US20120194661A1 (en) * | 2010-12-24 | 2012-08-02 | Gwangju Institute Of Science And Technology | Endscopic spectral domain optical coherence tomography system based on optical coherent fiber bundle |
| US20150351669A1 (en) * | 2013-01-22 | 2015-12-10 | Becton, Dickinson And Company | Reduced Size Optical Coupler for Fluorescence Detection |
| US9801578B2 (en) * | 2013-01-22 | 2017-10-31 | Becton, Dickinson And Company | Reduced size optical coupler for fluorescence detection |
Also Published As
| Publication number | Publication date |
|---|---|
| KR101380690B1 (ko) | 2014-04-02 |
| CN102438501B (zh) | 2014-10-15 |
| WO2010134342A4 (en) | 2011-03-17 |
| US20120057168A1 (en) | 2012-03-08 |
| US8836951B2 (en) | 2014-09-16 |
| JP2011005235A (ja) | 2011-01-13 |
| EP2432374A1 (en) | 2012-03-28 |
| KR20120018359A (ko) | 2012-03-02 |
| JP5627259B2 (ja) | 2014-11-19 |
| CN102438501A (zh) | 2012-05-02 |
Similar Documents
| Publication | Publication Date | Title |
|---|---|---|
| US8836951B2 (en) | Imaging device for optical coherence tomographic image and imaging method | |
| KR101496357B1 (ko) | 안과장치, 안과장치의 제어 방법, 및 기억매체 | |
| KR101570668B1 (ko) | 광간섭 단층촬상장치 | |
| US8982357B2 (en) | Imaging device and imaging method | |
| JP5623028B2 (ja) | 光干渉断層画像を撮る撮像方法及びその装置 | |
| US9955866B2 (en) | Optical tomographic imaging apparatus | |
| US9566001B2 (en) | Ophthalmologic apparatus | |
| US11950882B2 (en) | Single source photoacoustic remote sensing (SS-PARS) | |
| GB2407155A (en) | Spectral interferometry method and apparatus | |
| JP2014213156A (ja) | 光断層撮像装置 | |
| JP6498162B2 (ja) | 光断層撮像装置 | |
| US9427149B2 (en) | Optical tomographic imaging apparatus | |
| JP5995810B2 (ja) | 光断層撮像装置 | |
| JP6456444B2 (ja) | 眼底撮影装置 |
Legal Events
| Date | Code | Title | Description |
|---|---|---|---|
| WWE | Wipo information: entry into national phase |
Ref document number: 201080022514.7 Country of ref document: CN |
|
| 121 | Ep: the epo has been informed by wipo that ep was designated in this application |
Ref document number: 10725888 Country of ref document: EP Kind code of ref document: A1 |
|
| REEP | Request for entry into the european phase |
Ref document number: 2010725888 Country of ref document: EP |
|
| WWE | Wipo information: entry into national phase |
Ref document number: 2010725888 Country of ref document: EP |
|
| WWE | Wipo information: entry into national phase |
Ref document number: 13320740 Country of ref document: US |
|
| NENP | Non-entry into the national phase |
Ref country code: DE |
|
| ENP | Entry into the national phase |
Ref document number: 20117030118 Country of ref document: KR Kind code of ref document: A |